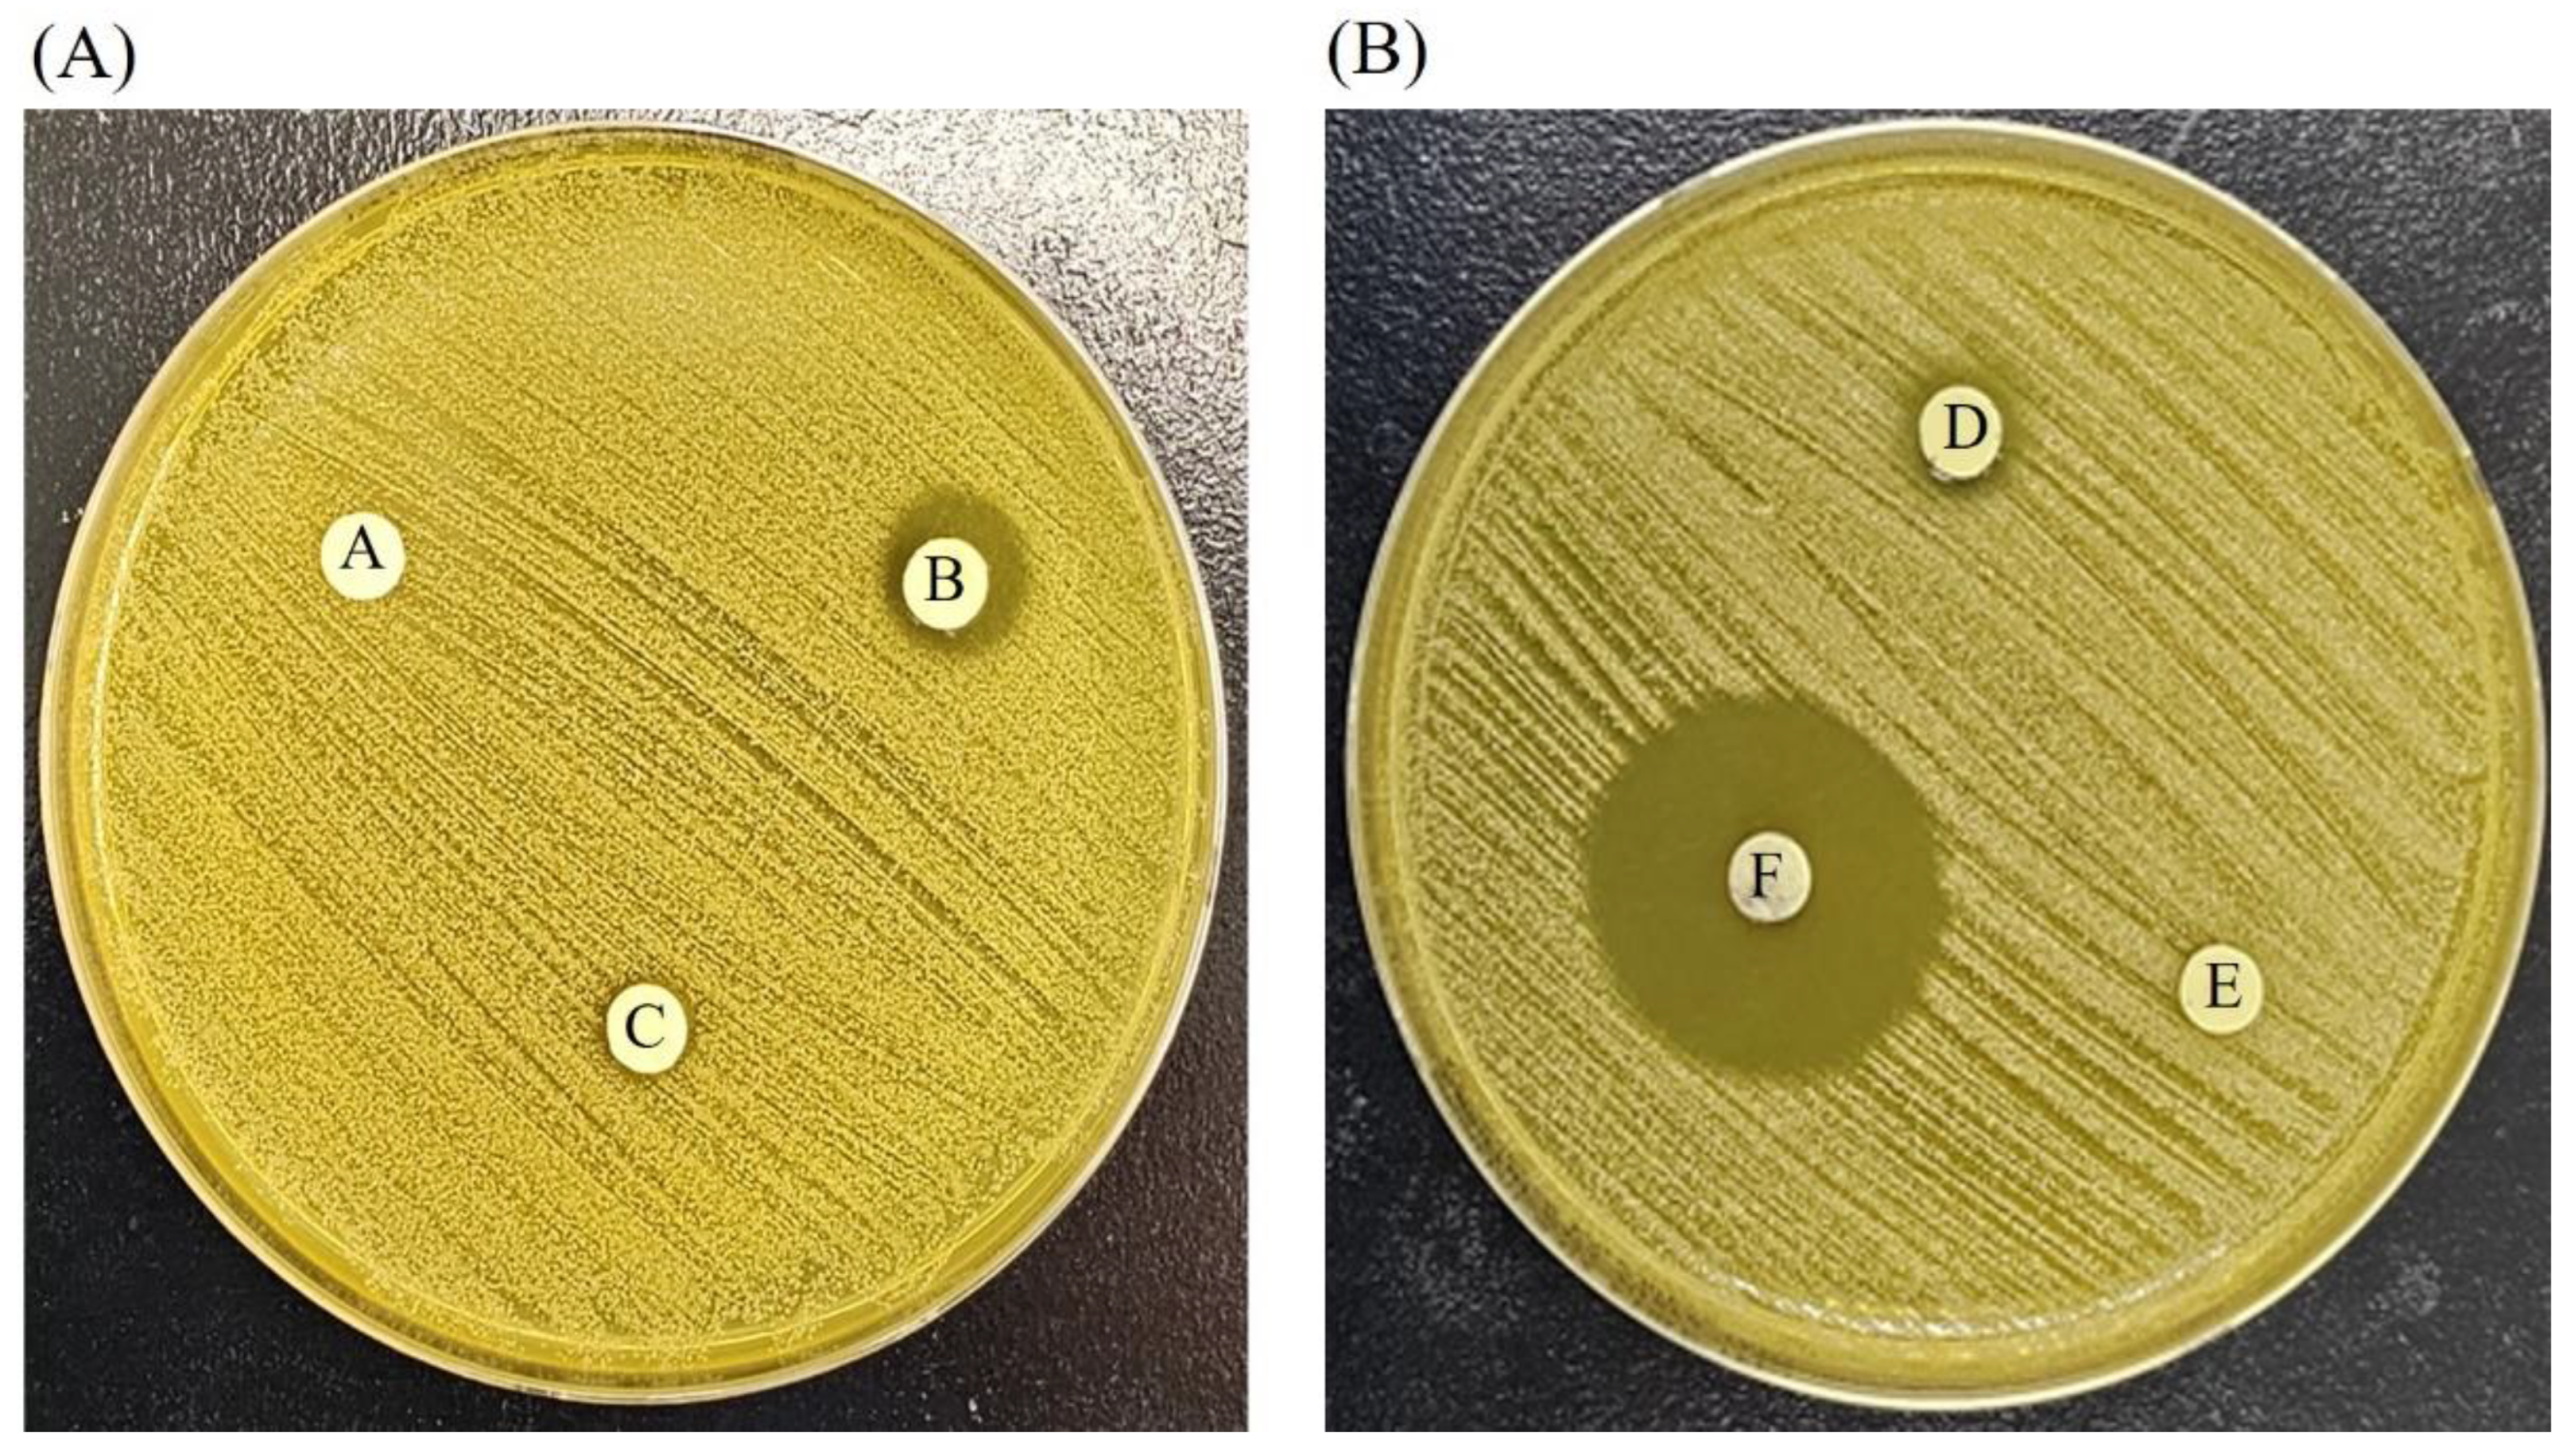
Medicina 59 00811 g010

Efficacy of Silver Nanoparticles-Loaded Bone Cement against an MRSA Induced-Osteomyelitis in a Rat Model
Abstract
1. Background
2. Methods
2.1. Fibroblast Isolation from Skin Tissue
2.2. Osteocytes Isolation from Calvaria
2.3. Cell Characterization
2.4. Cell Characterization
2.5. Antimicrobial Activity
2.6. Experimental Animals
2.7. Experimental Osteomyelitis
2.8. Insertion of AgNP-Containing Bone Cement
2.9. Bacterial Culture
2.10. Reverse Transcription Polymerase Chain Reaction (RT-PCR)
2.11. Bone Regeneration Analysis
2.12. Statistical Analysis
3. Results
3.1. Cell Characterization by Immunocytochemistry
3.2. Cell Viability
4. Osteomyelitis Characterization
5. Bacterial Culture of Infected and Treated Tibiae
6. Detection of MRSA Using RT-PCR
7. Bone Regeneration
8. Antimicrobial Activity of AgNPs against Resistant MRSA
9. Discussion
10. Conclusions
Author Contributions
Funding
Institutional Review Board Statement
Informed Consent Statement
Data Availability Statement
Acknowledgments
Conflicts of Interest
Abbreviations
References
- Mendelsohn, E.S.; Hoshino, C.M.; Harris, T.G.; Zinar, D.M. CT characterizing the anatomy of uninjured ankle syndesmosis. Orthopedics 2014, 37, e157–e160. [Google Scholar] [CrossRef]
- Montanaro, L.; Campoccia, D.; Arciola, C.R. Advancements in molecular epidemiology of implant infections and future perspectives. Biomaterials 2007, 28, 5155–5168. [Google Scholar] [CrossRef] [PubMed]
- Tan, H.; Lin, W.; Tang, T. The use of antimicrobial-impregnated PMMA to manage periprosthetic infections: Controversial issues and the latest developments. Int. J. Artif. Organs 2012, 35, 832–839. [Google Scholar] [CrossRef] [PubMed]
- Marriott, I. Apoptosis-associated uncoupling of bone formation and resorption in osteomyelitis. Front. Cell. Infect. Microbiol. 2013, 3, 101. [Google Scholar] [CrossRef]
- Cherng, A.; Takagi, S.; Chow, L. Effects of hydroxypropyl methylcellulose and other gelling agents on the handling properties of calcium phosphate cement. J. Biomed. Mater. Res. Off. J. Soc. Biomater. Jpn. Soc. Biomater. 1997, 35, 273–277. [Google Scholar] [CrossRef]
- Lew, D.P.; Waldvogel, F.A. Osteomyelitis. Lancet 2004, 364, 369–379. [Google Scholar] [CrossRef] [PubMed]
- Bose, S.; Tarafder, S. Calcium phosphate ceramic systems in growth factor and drug delivery for bone tissue engineering: A review. Acta Biomater. 2012, 8, 1401–1421. [Google Scholar] [CrossRef]
- Likus, W.; Bajor, G.; Siemianowicz, K. Nanosilver-does it have only one face? Acta Biochim. Pol. 2013, 60. [Google Scholar] [CrossRef]
- Gomes, D.; Pereira, M.; Bettencourt, A.F. Osteomyelitis: An overview of antimicrobial therapy. Braz. J. Pharm. Sci. 2013, 49, 13–27. [Google Scholar] [CrossRef]
- Dorozhkin, S.V. Calcium orthophosphate cements for biomedical application. J. Mater. Sci. 2008, 43, 3028–3057. [Google Scholar] [CrossRef]
- Brennan, S.A.; Ní Fhoghlú, C.; Devitt, B.; O’mahony, F.; Brabazon, D.; Walsh, A. Silver nanoparticles and their orthopaedic applications. Bone Jt. J. 2015, 97, 582–589. [Google Scholar] [CrossRef]
- Agrawal, S.; Bhatt, M.; Rai, S.K.; Bhatt, A.; Dangwal, P.; Agrawal, P.K. Silver nanoparticles and its potential applications: A review. J. Pharmacogn. Phytochem. 2018, 7, 930–937. [Google Scholar]
- Bee, S.-L.; Bustami, Y.; Ul-Hamid, A.; Lim, K.; Abdul Hamid, Z. Synthesis of silver nanoparticle-decorated hydroxyapatite nanocomposite with combined bioactivity and antibacterial properties. J. Mater. Sci. Mater. Med. 2021, 32, 106. [Google Scholar] [CrossRef] [PubMed]
- Schluesener, J.K.; Schluesener, H.J. Nanosilver: Application and novel aspects of toxicology. Arch. Toxicol. 2013, 87, 569–576. [Google Scholar] [CrossRef] [PubMed]
- Akiyama, T.; Miyamoto, H.; Yonekura, Y.; Tsukamoto, M.; Ando, Y.; Noda, I.; Sonohata, M.; Mawatari, M. Silver oxide-containing hydroxyapatite coating has in vivo antibacterial activity in the rat tibia. J. Orthop. Res. 2013, 31, 1195–1200. [Google Scholar] [CrossRef]
- Anwar, M.F.; Yadav, D.; Kapoor, S.; Chander, J.; Samim, M. Comparison of antibacterial activity of Ag nanoparticles synthesized from leaf extract of Parthenium hystrophorus L in aqueous media and gentamicin sulphate: In-vitro. Drug Dev. Ind. Pharm. 2015, 41, 43–50. [Google Scholar] [CrossRef]
- Ip, M.; Lui, S.L.; Poon, V.K.; Lung, I.; Burd, A. Antimicrobial activities of silver dressings: An in vitro comparison. J. Med. Microbiol. 2006, 55, 59–63. [Google Scholar] [CrossRef]
- He, Q.; Chen, H.; Huang, L.; Dong, J.; Guo, D.; Mao, M.; Kong, L.; Li, Y.; Wu, Z.; Lei, W. Porous surface modified bioactive bone cement for enhanced bone bonding. PLoS ONE 2012, 7, e42525. [Google Scholar] [CrossRef]
- Bauer, A. Antibiotic susceptibility testing by a standardized single diffusion method. Am. J. Clin. Pathol. 1966, 45, 493–496. [Google Scholar] [CrossRef]
- Jacquart, S.; Siadous, R.; Henocq-Pigasse, C.; Bareille, R.; Roques, C.; Rey, C.; Combes, C. Composition and properties of silver-containing calcium carbonate–calcium phosphate bone cement. J. Mater. Sci. Mater. Med. 2013, 24, 2665–2675. [Google Scholar] [CrossRef]
- Liu, H.-L.; Dai, S.A.; Fu, K.-Y.; Hsu, S.-h. Antibacterial properties of silver nanoparticles in three different sizes and their nanocomposites with a new waterborne polyurethane. Int. J. Nanomed. 2010, 5, 1017–1028. [Google Scholar]
- Martínez-Gutierrez, F.; Thi, E.P.; Silverman, J.M.; de Oliveira, C.C.; Svensson, S.L.; Hoek, A.V.; Sánchez, E.M.; Reiner, N.E.; Gaynor, E.C.; Pryzdial, E.L. Antibacterial activity, inflammatory response, coagulation and cytotoxicity effects of silver nanoparticles. Nanomed. Nanotechnol. Biol. Med. 2012, 8, 328–336. [Google Scholar] [CrossRef] [PubMed]
- Bartlomiejczyk, T.; Lankoff, A.; Kruszewski, M.; Szumiel, I. Silver nanoparticles–allies or adversaries? Ann. Agric. Environ. Med. 2013, 20, 48–54. [Google Scholar] [PubMed]
- Miethling-Graff, R.; Rumpker, R.; Richter, M.; Verano-Braga, T.; Kjeldsen, F.; Brewer, J.; Hoyland, J.; Rubahn, H.-G.; Erdmann, H. Exposure to silver nanoparticles induces size-and dose-dependent oxidative stress and cytotoxicity in human colon carcinoma cells. Toxicol. In Vitro 2014, 28, 1280–1289. [Google Scholar] [CrossRef]
- Arciola, C.R.; Campoccia, D.; Speziale, P.; Montanaro, L.; Costerton, J.W. Biofilm formation in Staphylococcus implant infections. A review of molecular mechanisms and implications for biofilm-resistant materials. Biomaterials 2012, 33, 5967–5982. [Google Scholar] [CrossRef] [PubMed]
- Faghri, J.; Zandi, A.; Peiman, A.; Fazeli, H.; Esfahani, B.N.; Safaei, H.G.; Hosseini, N.S.; Mobasherizadeh, S.; Sedighi, M.; Burbur, S. Study on Prevalence, Antibiotic Susceptibility, and tuf Gene Sequence–Based Genotyping of Species-Level of Coagulase-Negative Staphylococcus Isolated from Keratitis Caused by Using Soft Contact Lenses. Eye Contact Lens 2016, 42, 115–119. [Google Scholar] [CrossRef] [PubMed]
- Gillet, Y.; Issartel, B.; Vanhems, P.; Fournet, J.-C.; Lina, G.; Bes, M.; Vandenesch, F.; Piémont, Y.; Brousse, N.; Floret, D. Association between Staphylococcus aureus strains carrying gene for Panton-Valentine leukocidin and highly lethal necrotising pneumonia in young immunocompetent patients. Lancet 2002, 359, 753–759. [Google Scholar] [CrossRef]
- Fan, S.-Q.; Cai, J.-L.; Qin, L.-Y.; Wang, Z.-H.; Liu, Z.-Z.; Sun, M.-L. Effect of Heparin on Production of Transforming Growth Factor (TGF)-β1 and TGF-β1 mRNA Expression by Human Normal Skin and Hyperplastic Scar Fibroblasts. Ann. Plast. Surg. 2008, 60, 299–305. [Google Scholar] [CrossRef]
- Gu, G.; Nars, M.; Hentunen, T.A.; Metsikkö, K.; Väänänen, H.K. Isolated primary osteocytes express functional gap junctions in vitro. Cell Tissue Res. 2006, 323, 263–271. [Google Scholar] [CrossRef]
- Poeppl, W.; Tobudic, S.; Lingscheid, T.; Plasenzotti, R.; Kozakowski, N.; Lagler, H.; Georgopoulos, A.; Burgmann, H. Daptomycin, fosfomycin, or both for treatment of methicillin-resistant Staphylococcus aureus osteomyelitis in an experimental rat model. Antimicrob. Agents Chemother. 2011, 55, 4999–5003. [Google Scholar] [CrossRef]
- Stern, A.R.; Stern, M.M.; Van Dyke, M.E.; Jähn, K.; Prideaux, M.; Bonewald, L.F. Isolation and culture of primary osteocytes from the long bones of skeletally mature and aged mice. Biotechniques 2012, 52, 361–373. [Google Scholar] [CrossRef] [PubMed]
- Uçkay, I.; Jugun, K.; Gamulin, A.; Wagener, J.; Hoffmeyer, P.; Lew, D. Chronic osteomyelitis. Curr. Infect. Dis. Rep. 2012, 14, 566–575. [Google Scholar] [CrossRef] [PubMed]
- Ribeiro, M.; Monteiro, F.J.; Ferraz, M.P. Infection of orthopedic implants with emphasis on bacterial adhesion process and techniques used in studying bacterial-material interactions. Biomatter 2012, 2, 176–194. [Google Scholar] [CrossRef]
- Hassani Besheli, N.; Mottaghitalab, F.; Eslami, M.; Gholami, M.; Kundu, S.C.; Kaplan, D.L.; Farokhi, M. Sustainable release of vancomycin from silk fibroin nanoparticles for treating severe bone infection in rat tibia osteomyelitis model. ACS Appl. Mater. Interfaces 2017, 9, 5128–5138. [Google Scholar] [CrossRef] [PubMed]
- Qiu, X.-S.; Zheng, X.; Shi, H.-f.; Zhu, Y.-c.; Guo, X.; Mao, H.-j.; Xu, G.-y.; Chen, Y.-x. Antibiotic-impregnated cement spacer as definitive management for osteomyelitis. BMC Musculoskelet. Disord. 2015, 16, 1–5. [Google Scholar] [CrossRef]
- Zimmerli, W.; Sendi, P. Orthopaedic biofilm infections. APMIS 2017, 125, 353–364. [Google Scholar] [CrossRef]
- Caplin, J.D.; García, A.J. Implantable antimicrobial biomaterials for local drug delivery in bone infection models. Acta Biomater. 2019, 93, 2–11. [Google Scholar] [CrossRef]
- Durán, N.; Durán, M.; De Jesus, M.B.; Seabra, A.B.; Fávaro, W.J.; Nakazato, G. Silver nanoparticles: A new view on mechanistic aspects on antimicrobial activity. Nanomed. Nanotechnol. Biol. Med. 2016, 12, 789–799. [Google Scholar] [CrossRef] [PubMed]
- Tang, S.; Zheng, J. Antibacterial activity of silver nanoparticles: Structural effects. Adv. Healthc. Mater. 2018, 7, 1701503. [Google Scholar] [CrossRef]
- Chien, C.-S.; Lin, C.-J.; Ko, C.-J.; Tseng, S.-P.; Shih, C.-J. Antibacterial activity of silver nanoparticles (AgNP) confined to mesostructured silica against methicillin-resistant Staphylococcus aureus (MRSA). J. Alloys Compd. 2018, 747, 1–7. [Google Scholar] [CrossRef]
- Vergidis, P.; Rouse, M.S.; Euba, G.; Karau, M.J.; Schmidt, S.M.; Mandrekar, J.N.; Steckelberg, J.M.; Patel, R. Treatment with linezolid or vancomycin in combination with rifampin is effective in an animal model of methicillin-resistant Staphylococcus aureus foreign body osteomyelitis. Antimicrob. Agents Chemother. 2011, 55, 1182–1186. [Google Scholar] [CrossRef]
- Zou, S.B.; Yoon, W.Y.; Han, S.K.; Jeong, S.H.; Cui, Z.J.; Kim, W.K. Cytotoxicity of silver dressings on diabetic fibroblasts. Int. Wound J. 2013, 10, 306–312. [Google Scholar] [CrossRef] [PubMed]
- Song, M.-F.; Li, Y.-S.; Kasai, H.; Kawai, K. Metal nanoparticle-induced micronuclei and oxidative DNA damage in mice. J. Clin. Biochem. Nutr. 2012, 50, 211–216. [Google Scholar] [CrossRef]
- Kim, S.-H.; Lee, H.-S.; Ryu, D.-S.; Choi, S.-J.; Lee, D.-S. Antibacterial activity of silver-nanoparticles against Staphylococcus aureus and Escherichia coli. Microbiol. Biotechnol. Lett. 2011, 39, 77–85. [Google Scholar]
- Ydollahi, M.; Ahari, H.; Anvar, A.A. Antibacterial activity of silver-nanoparticles against Staphylococcus aureus. Afr. J. Microbiol. Res. 2016, 10, 850–855. [Google Scholar]
- Rai, M.; Yadav, A.; Gade, A. Silver nanoparticles as a new generation of antimicrobials. Biotechnol. Adv. 2009, 27, 76–83. [Google Scholar] [CrossRef] [PubMed]
- Aktekin, C.N.; Ozturk, A.M.; Tabak, A.Y.; Altay, M.; Korkusuz, F. A different perspective for radiological evaluation of experimental osteomyelitis. Skelet. Radiol. 2007, 36, 945–950. [Google Scholar] [CrossRef]
- Li, C.; Sun, J.; Shi, K.; Long, J.; Li, L.; Lai, Y.; Qin, L. Preparation and evaluation of osteogenic nano-MgO/PMMA bone cement for bone healing in a rat critical size calvarial defect. J. Mater. Chem. B 2020, 8, 4575–4586. [Google Scholar] [CrossRef]
- Li, W.-R.; Xie, X.-B.; Shi, Q.-S.; Duan, S.-S.; Ouyang, Y.-S.; Chen, Y.-B. Antibacterial effect of silver nanoparticles on Staphylococcus aureus. Biometals 2011, 24, 135–141. [Google Scholar] [CrossRef]
- Zhao, C.; Wu, L.; Wang, X.; Weng, S.; Ruan, Z.; Liu, Q.; Lin, L.; Lin, X. Quaternary ammonium carbon quantum dots as an antimicrobial agent against gram-positive bacteria for the treatment of MRSA-infected pneumonia in mice. Carbon 2020, 163, 70–84. [Google Scholar] [CrossRef]

Disclaimer/Publisher’s Note: The statements, opinions and data contained in all publications are solely those of the individual author(s) and contributor(s) and not of MDPI and/or the editor(s). MDPI and/or the editor(s) disclaim responsibility for any injury to people or property resulting from any ideas, methods, instructions or products referred to in the content. |
© 2023 by the authors. Licensee MDPI, Basel, Switzerland. This article is an open access article distributed under the terms and conditions of the Creative Commons Attribution (CC BY) license (https://creativecommons.org/licenses/by/4.0/).
Share and Cite
Choi, Y.S.; Kim, Y.H.; An, H.M.; Bae, S.K.; Lee, Y.K. Efficacy of Silver Nanoparticles-Loaded Bone Cement against an MRSA Induced-Osteomyelitis in a Rat Model. Medicina 2023, 59, 811. https://doi.org/10.3390/medicina59040811
Choi YS, Kim YH, An HM, Bae SK, Lee YK. Efficacy of Silver Nanoparticles-Loaded Bone Cement against an MRSA Induced-Osteomyelitis in a Rat Model. Medicina. 2023; 59(4):811. https://doi.org/10.3390/medicina59040811
Chicago/Turabian StyleChoi, Young Suk, Young Hwan Kim, Hye Min An, Sung Kyoung Bae, and Young Koo Lee. 2023. "Efficacy of Silver Nanoparticles-Loaded Bone Cement against an MRSA Induced-Osteomyelitis in a Rat Model" Medicina 59, no. 4: 811. https://doi.org/10.3390/medicina59040811
APA StyleChoi, Y. S., Kim, Y. H., An, H. M., Bae, S. K., & Lee, Y. K. (2023). Efficacy of Silver Nanoparticles-Loaded Bone Cement against an MRSA Induced-Osteomyelitis in a Rat Model. Medicina, 59(4), 811. https://doi.org/10.3390/medicina59040811

